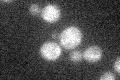

View description
High-affinity leucine permease, functions as a branched-chain amino acid permease involved in the uptake of leucine, isoleucine and valine; contains 12 predicted transmembrane domains
Localization:
Intensity:
Fold change:
Significance:
-
C’ GFP library in SD

below threshold14.64 -
N' NOP1pr-GFP in SD

ER42.8893 -
N' TEF2pr-mCherry in SD

cell periphery,vacuole53.5552 -
N' NATIVEpr-GFP in SD

missing0 -
N' TEF2pr-VC and Cyto-VN in SD

below threshold27.5501 -
C’ GFP library in SD+DTT

cytosol15.251.04No -
C’ GFP library in SD+H2O2
cytosol15.351.04No -
C’ GFP library in Starvation Media

cytosol18.451.25No -
C’ GFP library on the background of Pup2-DaMP

below threshold -
C’ GFP library on the background of CCT mutant

below threshold13.50190.92117No
